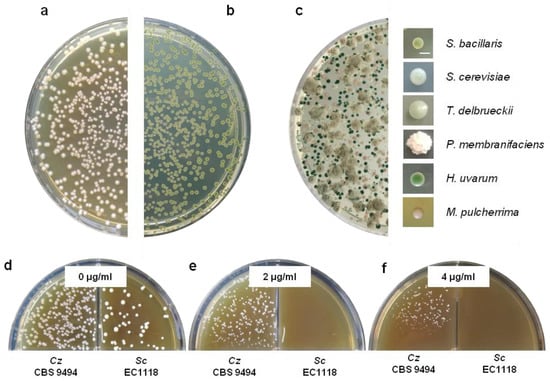

Abstract
Starmerella bacillaris (synonym Candida zemplinina) is a non-Saccharomyces yeast species, frequently found in enological ecosystems. Peculiar aspects of the genetics and metabolism of this yeast species, as well as potential industrial applications of isolated indigenous S. bacillaris strains worldwide, have recently been explored. In this review, we summarize relevant observations from studies conducted on standard laboratory and indigenous isolated S. bacillaris strains.
Keywords:
grape must; fermentation; wine; yeast; non-Saccharomyces; Starmerella bacillaris; Candida zemplinina 1. Introduction
Starmerella bacillaris (syn., Candida zemplinina; [1]) is a non-Saccharomyces yeast species frequently found in grapes and fermenting grape musts [2,3,4,5,6]. S. bacillaris, mainly isolated from sweet botrytized wines [3,7,8,9,10], has also been isolated from low-sugar fermenting grape musts from Vitis vinifera and other Vitis species [4,11,12,13], as well as from fruits, fruit-associated insects, and soil [3,14,15,16,17].
S. bacillaris was isolated and identified in Napa Valley (California, USA) from botrytis-affected wine fermentations (strain EJ1 [18]) and, shortly after, from fermenting botrytized grape musts in Zemplin, Hungary [9]. Following detailed morphological, physiological, and molecular characterization, the Hungarian isolates, which share D1/D2 sequences (i.e., large rDNA subunit) [19] with only two nucleotides of difference with the EJ1 Californian isolate, were proposed as part of the novel species, Candida zemplinina [9]. Additional studies (i.e., isoenzyme profiles, 26S rDNA restriction profiles and 26S rDNA sequencing), performed on the type strain of C. zemplinina (i.e., CBS 9494) and on two cultures of the neotype of Saccharomyces bacillaris (i.e., CBS 843 and PYCC 3044), confirmed that these three strains correspond to the same species. Because Saccharomyces bacillaris is the older epithet and has nomenclatural priority over C. zemplinina, Duarte et al., (2012) reinstated Sacch. bacillaris as Starmerella bacillaris comb. nov., with C. zemplinina as an obligate synonym [1].
Further studies have widely recognized S. bacillaris species (syn., C. zemplinina, type strain 10-372 T = CBS 9494T = NCAIM Y016667T) as a major non-Saccharomyces yeast at initial stages of spontaneously fermenting grape musts [6,11,20,21]. S. bacillaris has also been identified, along with Saccharomyces cerevisiae, at the end of alcoholic fermentations [22], suggesting that, in mixed fermentations with S. cerevisiae, S. bacillaris may coexist longer than other non-Saccharomyces species [22].
S. bacillaris has been described as an acidogenic, fructophilic, psychrotolerant, and highly osmotolerant microorganism [9,23,24]. The great genetic biodiversity found in isolates from different environments and the vast physiological diversity encountered in metabolic characterizations have contributed to interest in using this species as an industrial co-starter in fermented beverage production [7,8,25,26]. S. bacillaris has been characterized as a safe microorganism, which may encourage to its use as a biocontrol agent of several food pathogens [27].
In this review article, we discuss recent results from research into the genetics and genomics, ecology, population genetics and geographical biodiversity, metabolism, and ethanol production, as well as the biocontrol potential of S. bacillaris.
2. Genetic Aspects
2.1. Starmerella/Wickerhamiella Clade
S. bacillaris has been recognized as part of the W/S (Wickerhamiella and Starmerella) clade that branches close to Yarrowia lipolytica in the Saccharomycotina species tree [28]. A detailed phylogenetic tree of the W/S clade has recently been published [28]. Members of this clade are characterized by limited nutritional versatility, an unusually small cell size, and a strong association with the floral niche (i.e., flowers and insects that visit flowers) [28]. The Starmerella genera forms a well-supported subclade, with species usually presenting fermentative capacity, a trait normally absent in Wickerhamiella [28]. According to a comprehensive phylogenetic tree based on ITS1 sequences of 3942 fungal species, this Starmerella subclade does not include other enological non-Saccharomyces yeast species, suggesting a strong genetic divergence from the large wine yeast group [29]. The specific features present in Starmerella versus Wickerhamiella subclades probably result from the remodeling of important fluxes in central carbon metabolism as well as the reinstatement of other metabolic pathways [28]. Thus, the genera Starmerella harbors an unusually large number of genes of alien origin, which were shown to reconstruct the fermentative pathway in S. bacillaris [30], as well as other metabolic pathways, as shown in Starmerella bombicola [31,32]. For example, most of the genes in the thiamine salvage pathway in distinct subclades within the W/S lineage were originally acquired from bacteria by either horizontal gene transfer (HGT) or horizontal operon transfer (HOT) events [32]. In fact, S. bacillaris species lacks both THI5 and THI4 genes, required for de novo thiamine synthesis, but harbors the salvage pathway bacterial genes, THI6 and THI20, which allow the assimilation of thiamine derivatives from the environment [32]. Other potential HGT events in S. bacillaris populations, evolving in alternative non-conventional enological (i.e., non-V. vinifera; [11]), floral, and high sugar ecosystems, remain to be explored.
2.2. S. bacillaris Genome
S. bacillaris has three chromosomes [33]. A mean genome size of 9.3 Mb and G+C content of 39.4% have been recognized following sequencing of the genomes of C. zemplinina type strain CBS 9494 [2] and strains FRI751, PAS13, PYCC 3044, and NP2 [30,34,35,36]. Electrophoretic karyotyping showed the presence of two chromosomes of ~4 Mb each and one chromosome of ~1.8 Mb [33]. Genome alignment of two S. bacillaris strains (i.e., FRI751 and PAS13) evidenced the presence of five main chromosomal translocations, close to genes involved in mitochondrial and nucleotide metabolisms (i.e., endoplasmic reticulum protein-retaining receptor (KDEL), biosynthesis of aromatic amino acid protein (Aro1p), farnesyl diphosphate synthase (FDPS) protein, dUTP pyrophosphatase, cytochrome c oxidase subunit 2, and mitochondrial ribosomal protein of the large subunit) [29]. The chromosome alignments analyzed showed a general synteny between both genomes, with a high number of single nucleotide polymorphisms (SNPs) (i.e., 33,771 variants among 1146 putative genes) [29]. These observations highlight the large potential biodiversity among wild isolates of S. bacillaris, as has been reported by other authors [37,38,39].
2.3. S. bacillaris Ploidy and Microsatellite Loci
S. bacillaris has shown no evidence of sporulation ability [9], and it is considered haploid [38]. Interestingly, allele characterization for microsatellite loci CZ15 and CZ59 in S. bacillaris strain 11-6 suggested apparent heterozygosis for both loci [38]. A recent detailed analysis of S. bacillaris microsatellite loci CZ15 and CZ59, however, highlighted the molecular basis for the observed apparent heterozygosity [39]. The study, which included the analysis of the 10 S. bacillaris reference polymorphic microsatellite loci (i.e., CZ1, CZ4, CZ11, CZ13, CZ15, CZ20, CZ33, CZ45, CZ54, and CZ59; [38]), revealed a higher degree of structural complexity than expected from previous descriptions of yeast microsatellite loci [40,41,42,43,44]. In fact, alleles of alternative S. bacillaris microsatellite loci contain, in addition to the expected, and/or sometimes absent, variable lengths at their internal tandem-repeated motifs (TRM), extensive variations consisting of additional SNPs and/or insertions/deletions (indels), largely contributing to allelic variations [39]. In the case of loci CZ11 and CZ59, these alternative non-TRM sequences may explain the observed apparent heterozygosity in certain strains [39]. Interestingly, extension of these studies to microsatellite loci of S. cerevisiae and other common enological non-Saccharomyces species (i.e., Brettanomyces bruxellensis, Hanseniaspora uvarum, Meyerozyma guilliermondii, Saccharomyces uvarum, and Torulaspora delbrueckii) showed the existence of similar sequence and structural variants, potentially contributing to allele diversity [39]. These studies indicated that allele sizing of TRM polymorphic yeast microsatellite loci using PCR, although valid for strain differentiation and population genetic studies, does not necessarily score the number of units at their TRM [39]. Moreover, sequence analysis of microsatellite loci alleles could be used in evolutionary and phylogeny studies of yeast species [39].
2.4. S. bacillaris Species and Strain Identification
In addition to microsatellite loci, a large repertory of molecular strategies has been used to identify S. bacillaris isolates worldwide (Figure 1). Among these, restriction fragment length polymorphism (RFLP) analyses of 5.8S-ITS regions (Table 1) enable the identification of S. bacillaris isolates to species level, as well as differentiation of this yeast species from the close species, Candida stellata (i.e., DraI and MboI enzymes) [33] and Starmerella bombicola [45] (Table 1). Other molecular strategies have been used to characterize S. bacillaris to strain level, including SAU-PCR, RAPD-PCR, micro/minisatellites, and Rep-PCR, as well as AFLP-fingerprinting, mt-DNA-RFLP, and TRtRNA-PCR analyses [8,16,17,23,37,38,46]. Fingerprinting analyses, using SAU-PCR and Rep-PCR, have enabled recognition of genetic similarity between isolates from different sources [17,23] (Figure 1). Similarly, RAPD-PCR and SAU-PCR analyses showed a relative genetic homogeneity within Italian strains, with no differences in terms of strain clustering or geographic distribution [8]. The combination of different molecular strategies (i.e., polymorphic minisatellite loci, RAPD-PCR fingerprinting, and microsatellite primer (GTG)5 analyses) had a marked impact in population genetics analyses in S. bacillaris [16,46] (Figure 1). In addition, in situ fluorescence hybridization (FISH), targeting rRNA, has been optimized and validated as a culture-independent technique to monitor and identify S. bacillaris in biological samples [47].

Figure 1.
Worldwide diversity of S. bacillaris indigenous isolates. Genotypic studies of indigenous S. bacillaris strains show rich geographical diversity in Argentina (A1 and A2) [37]; France (F1) [38]; Greece (G1) [38]; Hungary (H1, H2, H3, H4, H5, and H6) [16]; Italy (I1) [10], (I2) [26], (I3) [23], and (I4) [38]; New Zealand (NZ1) [38]; Portugal–Azores Archipelago–(P1 and P2) [37]; Spain (Sp1) [38]; and Switzerland (S1 and S2) [16]. S. bacillaris isolates from V. vinifera and V. labrusca are indicated with magenta and green colors, respectively. The areas of the circles are proportional to the S. bacillaris strain diversity found in each study (i.e., higher area indicates higher diversity). S. bacillaris strains were identified from different sets of indigenous isolates using different molecular genotyping strategies. Strains over total isolates (strains/isolates) as well as their origin and molecular strategy used for identification were: 57/70 (A1) and 39/40 (A2) isolates from V. labrusca and V. vinifera musts, respectively, using PCR amplification of 10 microsatellite loci; 79/84 (F1) isolates from grape musts and fermenting grape musts, using PCR amplification of 10 microsatellite loci; 15/21 (G1) isolates from fermenting grape musts, using PCR amplification of 10 microsatellite loci; 2/6 (H1), 2/7 (H2), and 5/6 (H3) isolates from botrytized must, using RAPD-PCR amplification with primers 24, 128, and RF2; 5/6 (H4), 3/7 (H5), and 5/6 (H6) isolates from wine, using micro/minisatellite amplification with primers M13 and (GTG)5; 6/15 (I1) isolates from Vino Cotto, using RAPD-PCR amplification with primer M13; 9/63 (I2) isolates from grapes, using Sau-PCR amplification with primers SAG1 and SCA and Rep-PCR amplification with primer (GTG)5; 14/36 (I3) isolates from grapes, using Sau-PCR amplification; 14/18 (I4) isolates from musts, using PCR amplification of 10 microsatellite loci; 5/5 (NZ1) isolates from fermenting musts, using PCR amplification of 10 microsatellite loci; 13/13 (P1) and 3/4 (P2) isolates from V. labrusca grapes and V. vinifera musts, respectively, using PCR amplification of 10 microsatellite loci; 2/3 (S1) isolates from botrytized must, using micro/minisatellite amplification with primers M13 and (GTG)5; 3/3 (S2) isolates from wine, using RAPD-PCR amplification with primers 24, 128, and RF2; and 12/15 (Sp1) isolates from grape musts and fermenting musts, using PCR amplification of 10 microsatellite loci.

Table 1.
Digestion pattern of S. bacillaris ITS-5.8S region.
2.5. S. bacillaris Ecology
A detailed intraspecific genotype analysis in a large number of indigenous isolates of S. bacillaris, using 10 informative microsatellite loci, revealed a high degree of genetic heterogeneity [38] (Figure 1). In this study, genotypic characterization of 157 strains from various enological regions (i.e., 28 vineyards/wineries of France, Greece, Hungary, Italy, Spain, Switzerland, and New Zealand), as well as 6 strains from nature, revealed that populations isolated from winemaking environments are quite diverse [38]. Interestingly, neither clonal-like behavior nor specific genetic signatures were associated with strains isolated from different vineyards and wineries, the genetic diversity of S. bacillaris strains being shaped by geographical localization [38]. A further study involving the same 163 S. bacillaris strains, plus 127 strains isolated from V. vinifera and V. labrusca ecosystems of.
Argentina (Colonia Caroya, Córdoba) [11,12] and Portugal (Azores Archipelago) [4,5], reinforced the impact of geographic localization on S. bacillaris genetic population structure. This study also showed that Argentinian S. bacillaris populations are more differentiated from European populations than S. bacillaris populations within Europe [37]. In addition, no evidence of genetic differentiation based on the Vitis species or vintages, nor an evolving S. bacillaris population during alcoholic fermentation was found [37]. Overall, no genetic signature of S. bacillaris strains was found associated with different vintages, Vitis species, vineyards, and/or wineries, indicating that winemaking-related factors (i.e., Vitis species, vintage, alcoholic fermentation, and/or wineries) do not impact S. bacillaris population structure [37,38]. Thus, S. bacillaris is not under selective pressure in winemaking environments, representing an interesting model of a non-domesticated ubiquitous wine yeast species [37].
3. S. bacillaris Physiology
S. bacillaris grows as ellipsoid to elongated (2.2–3.0 mm × 3.0–5.2 mm) cells, which divide by multilateral budding [9] (Figure 2). Indigenous strains of this yeast species have been isolated worldwide, from grapes and grape musts, using the general yeast growth media YPD-agar (Figure 3a), the differential media WL-nutrient-agar (Figure 3b), and the selective media YPD agar, supplemented with cycloheximide (Figure 3d–f) and/or lysine-agar [20,48]. In standard YPD-agar media, S. bacillaris form small, white, creamy, shiny colonies (Figure 3a), while similar colonies, but green with a white peripheral halo, develop in WL-nutrient agar media (Figure 3b,c), which enables it to be differentiated from other non-Saccharomyces species (Figure 3c). Enological species of the Hanseniaspora genera (i.e., H. opuntiae, H. osmophila, H. uvarum, and H. vineae) also form green colonies in WL-nutrient agar, although these are larger and flat (see Figure 3c).

Figure 2.
S. bacillaris cell morphology. Cellular morphology of C. zemplinina (syn., S. bacillaris) strain CBS 9494 as observed under differential interference contrast (DIC) microscopy (a) or fluorescence (i.e., calcofluor-white staining) microscopy, which highlights cell walls and budding scars (b). Images were obtained using a Leica DMI8 inverted microscope and 63× objective.
Figure 3.
S. bacillaris colony morphology. Colonies of C. zemplinina (syn., S. bacillaris) strain CBS 9494 as observed in standard YPD (a) or differential WL-nutrient agar media (b), after incubation during 72 h at 25 °C. S. bacillaris forms small pale green, creamy colonies in WL-nutrient agar (b). “Multi-species” reconstitution experiment of common non-Saccharomyces yeasts (Hanseniaspora uvarum, Pichia membranifaciens, Metschnikowia pulcherrima, and Torulaspora delbrueckii), S. cerevisiae (strain EC1118), and C. zemplinina (strain CBS 9494) (c). The photography shows the particular morphology and color aspects, on WL-nutrient agar, of the various plated yeast species [49]. Bar in (c) represents 1 mm. Identical magnification for all colonies is shown. S. bacillaris (C. zemplinina CBS 9494; Cz) is resistant to cycloheximide (d–f), a phenotype that allows selective recognition of indigenous non-Saccharomyces compared to cycloheximide-sensitive S. cerevisiae strains (Sc) [20].
S. bacillaris can ferment glucose, sucrose, fructose, and raffinose, but not galactose, maltose, and lactose [9]. It shows a marked preference for fructose over glucose when both sugars are present simultaneously [7,10,25,50,51]. This fructophilic character is also associated with other yeast species found in high sugar environments (e.g., Candida apicola, Candida magnoliae, Candida versatilis, S. bombicola, Zygosaccharomyces bailii, and Zygosaccharomyces rouxii) [10,30,52]. Genetic evidence indicates that the fructophilic character of members of the W/S clade is dependent on a specific, low affinity, high capacity fructose transporter named “Ffz1” [52]. In silico analyses of S. bacillaris draft genome sequences showed the presence of two distinct FFZ1 genes at a distance of approximately 4 kb from each other [52]. These transporters (i.e., Ffz1a and Ffz1b) proved to enable growth on fructose and mannose when expressed as sole hexose transporters in a S. cerevisiae hxt-null mutant strain [52]. Kinetic parameters of these two transporters revealed that they are not functionally identical: Ffz1a more closely resembles the Ffz1 transporter from Z. rouxii, which seems to be indispensable for fructophily [53], while Ffz1b supports weaker growth on fructose and supports growth on mannose [52].
An interesting finding concerning fermentation in members of the W/S clade is the apparent absence of a typical pyruvate decarboxylase (PDC) enzyme [30]. In fact, decarboxylation of pyruvate to acetaldehyde is a key step in the alcoholic fermentative pathway, catalyzed by Pdc1 in S. cerevisiae [54,55,56]. Although orthologs of this gene appear to be absent in W/S-clade genomes, a modification of specificity in the enzyme Aro10, allowing this enzyme to accept pyruvate in addition to phenylpyruvate as a substrate, appears to be involved in the remodeling of alcoholic fermentation in W/S clade yeasts [30]. Furthermore, phylogenetic and kinetic analyses of putative alcohol dehydrogenase proteins, Adh1 and Adh6, present in the genomes of W/S-clade species, revealed that the corresponding ADH1 and ADH6 genes seem to have been horizontally transferred from bacteria [30]. Ethanol production in members of the W/S clade, conducted by alcohol dehydrogenases of bacterial origin, allow W/S clade species to maintain redox homeostasis (i.e., NAD+ regeneration) when growing under anaerobic conditions [30]. S. bacillaris, in particular, harbors one copy of an ADH1 xenolog; the ADH6 xenolog was apparently duplicated several times, as this yeast species harbors four ADH6 paralogs [30].
S. bacillaris uses higher sugar quantities (i.e., up to 40 g/L) than S. cerevisiae to produce 1% (v/v) ethanol [7,23,50,57]. This low ethanol yield, in addition to its low acetic acid production, of S. bacillaris compared to S. cerevisiae, reveals low activity of the acetaldehyde pathway in S. bacillaris, leading to a redistribution in the fluxes of the central carbon metabolism network [58]. Differently from other members of the W/S clade, which convert fructose directly into mannitol [31], S. bacillaris overproduces glycerol to maintain the NADH/NAD+ redox balance in the cells [31,58]. Thus, high glycerol levels are frequently reported for fermentations involving this yeast species [17,58,59,60,61]. Interestingly, different levels of glycerol production may be associated with alternative alleles of the GPP1 gene, encoding glycerol-3-phosphate phosphatase [29].
A reduced lag phase has been observed in S. bacillaris strains growing under low nitrogen conditions, suggesting a limited nitrogen requirement of this yeast species [51]. A preferential uptake of ammonium, tryptophan, and arginine, versus other poorly assimilated amino acids, has been observed in fermenting S. bacillaris cells [62]. The consumption of nitrogen sources by S. bacillaris revealed the strong inability of this species to take up most amino acids in the presence of ammonium [62]. However, nitrogen provided as ammonium versus a mixture of amino acids showed that organic nitrogen compounds supported more efficiently the growth of S. bacillaris [62].
Extracellular enzymes produced by S. bacillaris include β-glucosidase [50], proteases [26,50], and chitinases [26]. No pectinase, xylanase, lipase, or cellulase activities have yet been reported. The production of these enzymes may be finally dependent on the analyzed strain, the composition of the growing media, and/or the growth conditions [50]. For specific fermentation processes, it may be important to perform a detailed characterization of the extracellular enzymes secreted by S. bacillaris, to determine the final chemical profile of wines and/or to use this species as a biocontrol agent [26,27].
Subtle but significant differences have been observed for the various metabolic fermentative traits of S. bacillaris strains [16,17,50]. Fermentation vigor, tolerance to ethanol and acetic acid, and H2S production have been reported as more diverse than ethanol production [16,17,50]. In addition, these differences are affected by abiotic (e.g., nutrient availability, pH, oxygen levels, and temperature) and biotic (e.g., initial cell density and presence of other yeast species) factors [16,63]. Thus, as a warning, genetic similarities found among strains, following genotypic characterization, do not necessarily imply physiological similarities in S. bacillaris, and this should be taken into consideration when analyzing genotypic and phenotypic profile correlations [16,17].
4. Industrial Application of S. bacillaris
Non-Saccharomyces yeast co-starters offer enological advantages compared with single S. cerevisiae inoculations [64], contributing to more diverse organoleptic profiles of wines [60,65,66,67,68,69,70]. Due to its great genetic biodiversity and peculiar metabolism, S. bacillaris has been included as a potential co-starter yeast species for industrial mixed fermentations [60,65,71,72].
4.1. S. bacillaris as a Co-Starter in Grape Must Fermentations
In mixed alcoholic fermentations, S. bacillaris preferentially consume fructose, providing the evolving S. cerevisiae cell population with the use of glucose at both middle and later fermentation stages [60,73]. Thus, co-inoculation of S. bacillaris and S. cerevisiae strains can result in complete fermentation of the major sugars present in musts [59,63,73]. Moreover, mixed fermentations with S. bacillaris can also alleviate osmotic stress for the prevailing S. cerevisiae cells, improving fermentation kinetics and reducing acetic acid production [8,65,73,74]. S. bacillaris strains can also reduce the final contents of malic acid in wines [6,72,75,76]. This phenomenon appears to be dependent on the use by S. bacillaris of malic acid and/or on the stimulation of the malolactic activity of O. oeni, thus playing an indirect role in driving malolactic fermentation [75]. It has also been reported, however, that the inoculation of a S. bacillaris strain inhibited malolactic fermentation, possibly by the presence of inhibitory compounds that negatively affected the yeast-bacteria interaction [77].
S. bacillaris can normally maintain relatively high cell population levels up to the middle [25,60,78] or even to the final [73,79] stages of fermentation. This may have negative and/or antagonistic consequences of S. bacillaris in S. cerevisiae growth. In fact, mixed inoculations of S. cerevisiae with S. bacillaris can lead to a reduction in maximum S. cerevisiae populations in comparison with S. cerevisiae single starter fermentations [59,60,63,80]. This could be related to a decrease in nutrient concentrations in the must [25,60,78]. S. bacillaris death in mixed inoculated fermentations has also been investigated. Englezos et al. [79] demonstrated that high ethanol concentrations (~11.4% v/v) did not influence viability loss of S. bacillaris. What is more, it has been shown that S. bacillaris strains were able to grow at ethanol concentrations as high as 14% v/v, which could contribute to the successful implantation and good performance of this species during fermentations [10,17,50]. Other S. bacillaris isolates were reported to have low tolerance to alcohol levels (up to 5% v/v ethanol) [11,12]. Because the production of ethanol and other toxic metabolites by S. cerevisiae (such as killer toxins, SO2, and short- to medium-chain fatty acids) have not resulted in a negative co-existence of S. bacillaris’ populations [11,78], cell-to-cell contact mechanisms may be associated with S. bacillaris cell death [78]. Finally, it should be stressed that all reported S. bacillaris and S. cerevisiae interactions could be strain-specific more than species-specific [25,59].
4.2. S. bacillaris and the Reduction in Ethanol Levels in Wines
Due to its low ethanol yield, S. bacillaris is a promising yeast species to reduce ethanol contents in wines [25,50,57]. In recent years, for social, industrial, marketing, and health-associated reasons [81], there has been an increasing interest in reducing the final ethanol concentration of wines. With this aim, different technological and microbiological approaches, including the use of non-Saccharomyces starters, have been proposed [17,26,61,72]. Mixed culture fermentations of S. bacillaris and S. cerevisiae are normally differentiated from S. cerevisiae pure culture fermentations because of poor ethanol yields and high glycerol contents [25,50,51,59]. Interestingly, glycerol levels higher than 15 g/L have a positive effect on wine quality and sensory perception by contributing to wine structure and body perception [58].
4.3. Chemical Complexity of S. bacillaris and S. cerevisiae Fermented Beverages
Different complexities of fermented products can be obtained when performing single versus combined S. cerevisiae and/or S. bacillaris fermentations. Several authors have shown that, in laboratory scale fermentations, the concentrations of some aromatic compounds decline when using S. bacillaris and S. cerevisiae co-inoculums versus S. cerevisiae monocultures (Table 2) [27,58,60,63,65,82]. Other authors, however, have found an increase in volatile compounds when using mixed S. bacillaris and S. cerevisiae versus single yeast species fermentations [59]. S. bacillaris has been reported to overproduce compounds such as H2S, acetoin, ethyl acetate, and terpenes, which may have a negative impact on the wine organoleptic profile [23,49,61,63]. The apparent contradictory results regarding the sensory characteristics and chemical complexity of these studies could be dependent on: (i) the use of different S. bacillaris and S. cerevisiae strains, (ii) the inoculation procedures (i.e., simultaneous or sequential inoculations), (iii) the fermentation conditions (i.e., inoculum density, temperature, SO2, nitrogen and ethanol levels), and/or (iv) the grape must varieties analyzed [63,80,83] (Table 2). In some cases, these outcomes could be the consequence of either negative metabolic or synergistic interactions between S. bacillaris and S. cerevisiae strains [60,63,83]. Thus, a well-characterized set of co-starter strains and a proper design of the co-fermentations are essential factors to enhance or reduce the presence of particular metabolites [61,64,70]. Under these ideal co-fermentation conditions, the final wines would mimic the organoleptic profile of beverages obtained by spontaneous fermentations, where the local and/or regional sensorial identity of wines is enhanced [61,65,68].

Table 2.
Volatile metabolites in S. bacillaris and S. cerevisiae mixed fermentations.
Concerning the production of acetate and ethyl fatty esters, contradictory results have been obtained when using S. bacillaris in mixed fermentations (Table 2). In fact, mixed inoculations may result in increased [60,65,82,83] or reduced [58,63] overall levels of the various esters analyzed. Similar results were observed when analyzing higher alcohols. In these studies, S. bacillaris has been associated with either increased levels of total [82,83] and specific [58,59] or reduced [27,65] overall levels of these compounds (Table 2). Genome comparisons between two S. bacillaris strains (i.e., PAS13 and FRI751) and S. cerevisiae strain EC1118 revealed that the S. bacillaris branched-chain amino acid aminotransferase (BCAT) enzyme was strongly divergent from that of S. cerevisiae [29]. These differences in BCAT enzymes could influence valine, leucine and isoleucine degradation, and potentially the corresponding higher alcohol productions [29]. In the case of other aromatic compounds, like terpenes and C-13 norisoprenoids, their presence and relative concentration levels are related to the fermentation matrix (i.e., fruits and/or fruit varietals) and strain tested [27,58,63,83]. Again, either an increase or no change in their presence and relative levels was observed in S. cerevisiae and S. bacillaris mixed fermentations using alternative grape varietals and fruits and/or yeast strains (Table 2).
Production of H2S by S. bacillaris seems to also be variable and strain-specific. Different authors have reported high [17], medium [12,17,23], and low [23,84] H2S production from S. bacillaris strains. In some studies, the temperature of the fermentations has been considered, because production of H2S seems to increase at higher temperatures [50]. Mixed inoculations using S. cerevisiae and S. bacillaris result in wines with higher levels of sulfur compounds [74]. Other undesirable compounds, like volatile fatty acids, showed a reduction in mixed fermentations with S. cerevisiae and S. bacillaris [58,82,83]. Low production of acetic acid by S. bacillaris strains, either in pure or in mixed fermentations, has been reported [6,17,23,25,51,60,61,63,74]. Other S. bacillaris strains, however, have been shown to produce relatively high levels of acetic acid [50].
4.4. Biocontrol Potential of S. bacillaris
S. bacillaris strains have been studied as a safe and eco-friendly method to control several diseases affecting fruit crops and their associated products [26,27]. Lemos Junior et al. (2020) reported the absence of pathogenicity factors for human health of S. bacillaris strains, including growth at 37 °C, pseudohyphae formation, invasive growth, and proteolytic activity, which guarantees that these strains do not represent a risk for human health [27]. Even when S. bacillaris has been associated with table grape sour rot [85], the use of S. bacillaris may control several fungal diseases and may also present a potential positive impact on subsequent fermentations [26,27].
The biocontrol activity of selected S. bacillaris strains has been studied against the gray mold disease agent, Botrytis cinerea, in apples and grapes [26,27]. These studies showed that the possible antifungal mode of action of this species is volatile organic compound (VOC) production, which, in turn, present inhibitory effects both in vivo and in vitro [26,27]. VOCs are suggested as the main compounds responsible for the reduction in fungal radial mycelial growth and B. cinerea gray mold decay [26,27], possibly due to the antimicrobial action of benzyl alcohol. In addition, Alternaria alternata grape infections and toxin production [86] have been successfully controlled by the use of S. bacillaris strains. The biocontrol of A. alternata could be the result of S. bacillaris’ ability to colonize wound sites, which implies competitive mechanisms [86].
5. Conclusions
Starmerella bacillaris (syn., C. zemplinina) is a fructophilic non-Saccharomyces yeast species ubiquitously present in grapes, grape musts, and flowers. Surprising recent findings concerning the genetic diversity and metabolism of S. bacillaris have positioned this yeast species as an important model microorganism for evolutionary and metabolic studies, as well as the potential industrial and biocontrol uses. Detailed population genetic analyses of the S. bacillaris species, and comparative genomic studies in the genera Starmerella, have revealed the rich diversity of S. bacillaris worldwide, as well as the existence of complex HGT events that have exquisitely redesigned some metabolic pathways. These observations open a path for further studies on ecological and evolutionary aspects of the metabolism in S. bacillaris. Finally, the selection of unique, enologically advantageous S. bacillaris co-starter strains showing desired fermentation profiles would contribute to satisfy winemakers’ and the consumer’s expectations.
Author Contributions
Conceptualization, M.L.R.E. and A.L.R.; investigation, M.L.R.E. and A.L.R.; writing—original draft preparation, M.L.R.E. and A.L.R.; writing—review and editing, M.L.R.E. and A.L.R.; funding acquisition, A.L.R. All authors have read and agreed to the published version of the manuscript.
Funding
This research was funded by FONCYT (Argentina), grant number PICT-2014-3113, and by Universidad Católica de Córdoba grant number SIV-2015. M.L.R.E. is supported by a fellowship from the Argentine National Research Council (CONICET) and A.L.R. is a Principal Investigator of CONICET (Argentina).
Institutional Review Board Statement
Not applicable.
Informed Consent Statement
Not applicable.
Data Availability Statement
Not applicable.
Acknowledgments
We thank J. Drumonde-Neves for sharing S. bacillaris isolates (Azores Archipelago, Portugal) and M. Bely, I. Masneuf-Pomarede, W. Albertin, and P. Marullo (ISVV-Bordeaux, France) for sharing strains and expertise on wine yeast characterization. J. Heywood is acknowledged for English editing.
Conflicts of Interest
The authors declare no conflict of interest.
References
- Duarte, F.L.; Pimentel, N.H.; Teixeira, A.; Fonseca, A. Saccharomyces bacillaris is not a synonym of Candida stellata: Reinstatement as Starmerella bacillaris comb. nov. Antonie Van Leeuwenhoek 2012, 102, 653–658. [Google Scholar] [CrossRef] [PubMed]
- Rosa, A.L.; Miot-Sertier, C.; Salin, F.; Sipiczki, M.; Bely, M. Draft Genome Sequence of the Starmerella bacillaris (syn., Candida zemplinina) Type Strain CBS 9494. Microbiol. Resour. Announc. 2018, 7, 1–4. [Google Scholar] [CrossRef] [PubMed]
- Csoma, H.; Sipiczki, M. Taxonomic reclassification of Candida stellata strains reveals frequent occurrence of Candida zemplinina in wine fermentation. FEMS Yeast Res. 2008, 8, 328–336. [Google Scholar] [CrossRef] [PubMed]
- Drumonde-Neves, J.; Franco-Duarte, R.; Lima, T.; Schuller, D.; Pais, C. Yeast biodiversity in vineyard environments is increased by human intervention. PLoS ONE 2016, 11, e0160579. [Google Scholar] [CrossRef] [PubMed]
- Drumonde-Neves, J.; Franco-Duarte, R.; Lima, T.; Schuller, D.; Pais, C. Association between grape yeast communities and the vineyard ecosystems. PLoS ONE 2017, 12, e0169883. [Google Scholar] [CrossRef]
- Tofalo, R.; Schirone, M.; Torriani, S.; Rantsiou, K.; Cocolin, L.; Perpetuini, G.; Suzzi, G. Diversity of Candida zemplinina strains from grapes and Italian wines. Food Microbiol. 2012, 29, 18–26. [Google Scholar] [CrossRef]
- Magyar, I.; Tóth, T. Comparative evaluation of some oenological properties in wine strains of Candida stellata, Candida zemplinina, Saccharomyces uvarum and Saccharomyces cerevisiae. Food Microbiol. 2011, 28, 94–100. [Google Scholar] [CrossRef]
- Rantsiou, K.; Dolci, P.; Giacosa, S.; Torchio, F.; Tofalo, R.; Torriani, S.; Suzzi, G.; Rolle, L.; Cocolin, L. Candida zemplinina can reduce acetic acid produced by Saccharomyces cerevisiae in sweet wine fermentations. Appl. Environ. Microbiol. 2012, 78, 1987–1994. [Google Scholar] [CrossRef]
- Sipiczki, M. Candida zemplinina sp. nov., an osmotolerant and psychrotolerant yeast that ferments sweet botrytized wines. Int. J. Syst. Evol. Microbiol. 2003, 53, 2079–2083. [Google Scholar] [CrossRef]
- Tofalo, R.; Chaves-López, C.; Di Fabio, F.; Schirone, M.; Felis, G.E.; Torriani, S.; Paparella, A.; Suzzi, G. Molecular identification and osmotolerant profile of wine yeasts that ferment a high sugar grape must. Int. J. Food Microbiol. 2009, 130, 179–187. [Google Scholar] [CrossRef]
- Raymond Eder, M.L.; Reynoso, C.; Lauret, S.C.; Rosa, A.L. Isolation and identification of the indigenous yeast population during spontaneous fermentation of Isabella (Vitis labrusca L.) grape must. Front. Microbiol. 2017, 8, 1–8. [Google Scholar] [CrossRef] [PubMed]
- Raymond Eder, M.L.; Conti, F.; Rosa, A.L. Differences between indigenous yeast populations in spontaneously fermenting musts from V. vinifera L. and V. labrusca L. Grapes harvested in the same geographic location. Front. Microbiol. 2018, 9, 1–10. [Google Scholar] [CrossRef] [PubMed]
- Gaensly, F.; Agustini, B.C.; da Silva, G.A.; Picheth, G.; Bonfim, T.M.B. Autochthonous yeasts with β-glucosidase activity increase resveratrol concentration during the alcoholic fermentation of Vitis labrusca grape must. J. Funct. Foods 2015, 19, 288–295. [Google Scholar] [CrossRef]
- Stamps, J.A.; Yang, L.H.; Morales, V.M.; Boundy-Mills, K.L. Drosophila regulate yeast density and increase yeast community similarity in a natural substrate. PLoS ONE 2012, 7, e42238. [Google Scholar] [CrossRef] [PubMed]
- Nielsen, D.S.; Hønholt, S.; Tano-Debrah, K.; Jespersen, L. Yeast populations associated with Ghanaian cocoa fermentations analysed using denaturing gradient gel electrophoresis (DGGE). Yeast 2005, 22, 271–284. [Google Scholar] [CrossRef]
- Pfliegler, W.P.; Horváth, E.; Kállai, Z.; Sipiczki, M. Diversity of Candida zemplinina isolates inferred from RAPD, micro/minisatellite and physiological analysis. Microbiol. Res. 2014, 169, 402–410. [Google Scholar] [CrossRef]
- Binati, R.L.; Innocente, G.; Gatto, V.; Celebrin, A.; Polo, M.; Felis, G.E.; Torriani, S. Exploring the diversity of a collection of native non-Saccharomyces yeasts to develop co-starter cultures for winemaking. Food Res. Int. 2019, 122, 432–442. [Google Scholar] [CrossRef]
- Mills, D.A.; Johannsen, E.A.; Cocolin, L. Yeast diversity and persistence in botrytis-affected wine fermentations. Appl. Environ. Microbiol. 2002, 68, 4884–4893. [Google Scholar] [CrossRef] [PubMed]
- Kurtzman, C.P.; Robnett, C.J. Identification and phylogeny of ascomycetous yeasts from analysis of nuclear large subunit (26S) ribosomal DNA partial sequences. Antonie van Leeuwenhoek Int. J. Gen. Mol. Microbiol. 1998, 73, 331–371. [Google Scholar] [CrossRef] [PubMed]
- Zott, K.; Miot-Sertier, C.; Claisse, O.; Lonvaud-Funel, A.; Masneuf-Pomarede, I. Dynamics and diversity of non-Saccharomyces yeasts during the early stages in winemaking. Int. J. Food Microbiol. 2008, 125, 197–203. [Google Scholar] [CrossRef] [PubMed]
- Padilla, B.; Gil, J.V.; Manzanares, P. Past and future of non-Saccharomyces yeasts: From spoilage microorganisms to biotechnological tools for improving wine aroma complexity. Front. Microbiol. 2016, 7, 1–20. [Google Scholar] [CrossRef] [PubMed]
- Wang, C.; Mas, A.; Esteve-Zarzoso, B. The interaction between Saccharomyces cerevisiae and non-Saccharomyces yeast during alcoholic fermentation is species and strain specific. Front. Microbiol. 2016, 7, 1–11. [Google Scholar] [CrossRef] [PubMed]
- Englezos, V.; Rantsiou, K.; Torchio, F.; Rolle, L.; Gerbi, V.; Cocolin, L. Exploitation of the non-Saccharomyces yeast Starmerella bacillaris (synonym Candida zemplinina) in wine fermentation: Physiological and molecular characterizations. Int. J. Food Microbiol. 2015, 199, 33–40. [Google Scholar] [CrossRef] [PubMed]
- Magyar, I.; Nyitrai-Sárdy, D.; Leskó, A.; Pomázi, A.; Kállay, M. Anaerobic organic acid metabolism of Candida zemplinina in comparison with Saccharomyces wine yeasts. Int. J. Food Microbiol. 2014, 178, 1–6. [Google Scholar] [CrossRef] [PubMed]
- Englezos, V.; Rantsiou, K.; Cravero, F.; Torchio, F.; Ortiz-Julien, A.; Gerbi, V.; Rolle, L.; Cocolin, L. Starmerella bacillaris and Saccharomyces cerevisiae mixed fermentations to reduce ethanol content in wine. Appl. Microbiol. Biotechnol. 2016, 100, 5515–5526. [Google Scholar] [CrossRef]
- Lemos Junior, W.J.F.; Bovo, B.; Nadai, C.; Crosato, G.; Carlot, M.; Favaron, F.; Giacomini, A.; Corich, V. Biocontrol ability and action mechanism of Starmerella bacillaris (Synonym Candida zemplinina) isolated from wine musts against gray mold disease agent Botrytis cinerea on grape and their effects on alcoholic fermentation. Front. Microbiol. 2016, 7, 1–12. [Google Scholar] [CrossRef]
- Junior, W.J.; Binati, R.L.; Felis, G.E.; Slaghenaufi, D.; Ugliano, M.; Torriani, S. Volatile organic compounds from Starmerella bacillaris to control gray mold on apples and modulate cider aroma profile. Food Microbiol. 2020, 89. [Google Scholar] [CrossRef]
- Gonçalves, P.; Gonçalves, C.; Brito, P.H.; Sampaio, J.P. The Wickerhamiella/Starmerella clade—A treasure trove for the study of the evolution of yeast metabolism. Yeast 2020, 37, 313–320. [Google Scholar] [CrossRef]
- Lemos Junior, W.J.; da Silva Duarte, V.; Treu, L.; Campanaro, S.; Nadai, C.; Giacomini, A.; Corich, V. Whole genome comparison of two Starmerella bacillaris strains with other wine yeasts uncovers genes involved in modulating important winemaking traits. FEMS Yeast Res. 2018, 18, foy069. [Google Scholar] [CrossRef]
- Gonçalves, C.; Wisecaver, J.H.; Kominek, J.; Salema-Oom, M.; Leandro, M.J.; Shen, X.X.; Opulente, D.A.; Zhou, X.; Peris, D.; Kurtzman, C.P.; et al. Evidence for loss and reacquisition of alcoholic fermentation in a fructophilic yeast lineage. eLife 2018, 7, e33034. [Google Scholar] [CrossRef]
- Gonçalves, C.; Ferreira, C.; Gonçalves, L.G.; Turner, D.L.; Leandro, M.J.; Salema-Oom, M.; Santos, H.; Gonçalves, P. A New Pathway for Mannitol Metabolism in Yeasts Suggests a Link to the Evolution of Alcoholic Fermentation. Front. Microbiol. 2019, 10, 2510. [Google Scholar] [CrossRef]
- Gonçalves, C.; Gonçalves, P. Multilayered horizontal operon transfers from bacteria reconstruct a thiamine salvage pathway in yeasts. Proc. Natl. Acad. Sci. USA 2019, 116, 22219–22228. [Google Scholar] [CrossRef] [PubMed]
- Sipiczki, M. Species identification and comparative molecular and physiological analysis of Candida zemplinina and Candida stellata. J. Basic Microbiol. 2004, 44, 471–479. [Google Scholar] [CrossRef] [PubMed]
- Junior, W.J.; Treu, L.; da Silva Duarte, V.; Campanaro, S.; Nadai, C.; Giacomini, A.; Corich, V. Draft genome sequence of the yeast Starmerella bacillaris (syn., Candida zemplinina) FRI751 isolated from fermenting must of dried Raboso grapes. Genome Announc. 2017, 5. [Google Scholar] [CrossRef]
- Lemos Junior, W.J.F.; Treu, L.; da Silva Duarte, V.; Carlot, M.; Nadai, C.; Campanaro, S.; Giacomini, A.; Corich, V. Whole-genome sequence of Starmerella bacillaris PAS13, a nonconventional enological yeast with antifungal activity. Genome Announc. 2017, 5. [Google Scholar] [CrossRef]
- Ko, H.-J.; Park, H.J.; Lee, S.H.; Jeong, H.; Bae, J.-H.; Sung, B.H.; Choi, I.-G.; Sohn, J.-H. Draft genome sequence of an acid-tolerant yeast, Candida zemplinina NP2, a potential producer of organic acids. Genome Announc. 2017, 5. [Google Scholar] [CrossRef] [PubMed]
- Raymond Eder, M.L.; Conti, F.; Bely, M.; Masneuf-Pomarède, I.; Albertin, W.; Rosa, A.L. Vitis species, vintage, and alcoholic fermentation do not drive population structure in Starmerella bacillaris (synonym Candida zemplinina) species. Yeast 2019, 36, 411–420. [Google Scholar] [CrossRef]
- Masneuf-Pomarède, I.; Juquin, E.; Miot-Sertier, C.; Renault, P.; Laizet, Y.; Salin, F.; Alexandre, H.; Capozzi, V.; Cocolin, L.; Colonna-Ceccaldi, B.; et al. The yeast Starmerella bacillaris (synonym Candida zemplinina) shows high genetic diversity in winemaking environments. FEMS Yeast Res. 2015, 15, fov045. [Google Scholar] [CrossRef] [PubMed]
- Raymond Eder, M.L.; Rosa, A.L. Non-tandem repeat polymorphisms at microsatellite loci in wine yeast species. Mol. Genet. Genom. 2020, 295, 685–693. [Google Scholar] [CrossRef]
- Legras, J.L.; Ruh, O.; Merdinoglu, D.; Karst, F. Selection of hypervariable microsatellite loci for the characterization of Saccharomyces cerevisiae strains. Int. J. Food Microbiol. 2005, 102, 73–83. [Google Scholar] [CrossRef] [PubMed]
- Hranilovic, A.; Bely, M.; Masneuf-Pomarede, I.; Jiranek, V.; Albertin, W. The evolution of Lachancea thermotolerans is driven by geographical determination, anthropisation and flux between different ecosystems. PLoS ONE 2017, 12, e0184652. [Google Scholar] [CrossRef] [PubMed]
- Masneuf-Pomarede, I.; Salin, F.; Börlin, M.; Coton, E.; Coton, M.; Le Jeune, C.; Legras, J.L. Microsatellite analysis of Saccharomyces uvarum diversity. FEMS Yeast Res. 2016, 16. [Google Scholar] [CrossRef] [PubMed]
- Albertin, W.; Chasseriaud, L.; Comte, G.; Panfili, A.; Delcamp, A.; Salin, F.; Marullo, P.; Bely, M. Winemaking and bioprocesses strongly shaped the genetic diversity of the ubiquitous yeast Torulaspora delbrueckii. PLoS ONE 2014, 9, e94246. [Google Scholar] [CrossRef]
- Albertin, W.; Panfili, A.; Miot-Sertier, C.; Goulielmakis, A.; Delcamp, A.; Salin, F.; Lonvaud-Funel, A.; Curtin, C.D.; Masneuf-Pomarede, I. Development of microsatellite markers for the rapid and reliable genotyping of Brettanomyces bruxellensis at strain level. Food Microbiol. 2014, 42, 188–195. [Google Scholar] [CrossRef]
- García, M.; Esteve-Zarzoso, B.; Cabellos, J.M.; Arroyo, T. Advances in the study of Candida stellata. Fermentation 2018, 4, 74. [Google Scholar] [CrossRef]
- Csoma, H.; Ács-Szabó, L.; Papp, L.A.; Sipiczki, M. Application of different markers and data-analysis tools to the examination of biodiversity can lead to different results: A case study with Starmerella bacillaris (synonym Candida zemplinina) strains. FEMS Yeast Res. 2018. [Google Scholar] [CrossRef]
- Wang, C.; Esteve-Zarzoso, B.; Mas, A. Monitoring of Saccharomyces cerevisiae, Hanseniaspora uvarum, and Starmerella bacillaris (synonym Candida zemplinina) populations during alcoholic fermentation by fluorescence in situ hybridization. Int. J. Food Microbiol. 2014, 191, 1–9. [Google Scholar] [CrossRef]
- Heard, G.M.; Fleet, G.H. Evaluation of selective media for enumeration of yeasts during wine fermentation. J. Appl. Bacteriol. 1986, 60, 477–481. [Google Scholar] [CrossRef]
- Chasseriaud, L.; Coulon, J.; Marullo, P.; Albertin, W.; Bely, M. New oenological practice to promote non-Saccharomyces species of interest: Saturating grape juice with carbon dioxide. Appl. Microbiol. Biotechnol. 2018, 102, 3779–3791. [Google Scholar] [CrossRef]
- Mestre Furlani, M.V.; Maturano, Y.P.; Combina, M.; Mercado, L.A.; Toro, M.E.; Vazquez, F. Selection of non-Saccharomyces yeasts to be used in grape musts with high alcoholic potential: A strategy to obtain wines with reduced ethanol content. FEMS Yeast Res. 2017, 17, fox010. [Google Scholar] [CrossRef] [PubMed]
- Lemos Junior, W.J.F.; Nadai, C.; Crepalde, L.T.; de Oliveira, V.S.; Dupas de Matos, A.; Giacomini, A.; Corich, V. Potential use of Starmerella bacillaris as fermentation starter for the production of low-alcohol beverages obtained from unripe grapes. Int. J. Food Microbiol. 2019, 303, 1–8. [Google Scholar] [CrossRef]
- Gonçalves, C.; Coelho, M.A.; Salema-Oom, M.; Gonçalves, P. Stepwise functional evolution in a fungal sugar transporter family. Mol. Biol. Evol. 2016, 33, 352–366. [Google Scholar] [CrossRef] [PubMed]
- Leandro, M.J.; Cabral, S.; Prista, C.; Loureiro-Dias, M.C.; Sychrová, H. The high-capacity specific fructose facilitator ZrFfz1 is essential for the fructophilic behavior of Zygosaccharomyces rouxii CBS 732T. Eukaryot. Cell 2014, 13, 1371–1379. [Google Scholar] [CrossRef] [PubMed]
- Flikweert, M.T.; Van Der Zanden, L.; Janssen, W.M.; Steensma, H.Y.; Van Dijken, J.P.; Pronk, J.T. Pyruvate decarboxylase: An indispensable enzyme for growth of Saccharomyces cerevisiae on glucose. Yeast 1996, 12, 247–257. [Google Scholar] [CrossRef]
- Flikweert, M.T.; de Swaaf, M.; van Dijken, J.P.; Pronk, J.T. Growth requirements of pyruvate-decarboxylase-negative Saccharomyces cerevisiae. FEMS Microbiol. Lett. 1999, 174, 73–79. [Google Scholar] [CrossRef][Green Version]
- Barnett, J.A. Beginnings of microbiology and biochemistry: The contribution of yeast research. Microbiology 2003, 149, 557–567. [Google Scholar] [CrossRef] [PubMed]
- Bely, M.; Sicard, D.; Bely, M.; Renault, P.; Silva, T.; Masneuf-Pomarède, I.; Albertin, W. Non-conventional yeasts and alcohol level reduction. BIO Web Conf. 2013, 33. [Google Scholar] [CrossRef]
- Englezos, V.; Rantsiou, K.; Cravero, F.; Torchio, F.; Giacosa, S.; Ortiz-Julien, A.; Gerbi, V.; Rolle, L.; Cocolin, L. Volatile profiles and chromatic characteristics of red wines produced with Starmerella bacillaris and Saccharomyces cerevisiae. Food Res. Int. 2018, 109, 298–309. [Google Scholar] [CrossRef]
- Englezos, V.; Pollon, M.; Rantsiou, K.; Ortiz-Julien, A.; Botto, R.; Río Segade, S.; Giacosa, S.; Rolle, L.; Cocolin, L. Saccharomyces cerevisiae-Starmerella bacillaris strains interaction modulates chemical and volatile profile in red wine mixed fermentations. Food Res. Int. 2019, 122, 392–401. [Google Scholar] [CrossRef] [PubMed]
- Nisiotou, A.; Sgouros, G.; Mallouchos, A.; Nisiotis, C.S.; Michaelidis, C.; Tassou, C.; Banilas, G. The use of indigenous Saccharomyces cerevisiae and Starmerella bacillaris strains as a tool to create chemical complexity in local wines. Food Res. Int. 2018, 111, 498–508. [Google Scholar] [CrossRef]
- Suzzi, G.; Schirone, M.; Sergi, M.; Marianella, R.M.; Fasoli, G.; Aguzzi, I.; Tofalo, R. Multistarter from organic viticulture for red wine Montepulciano d’Abruzzo production. Front. Microbiol. 2012, 3, 1–10. [Google Scholar] [CrossRef]
- Englezos, V.; Cocolin, L.; Rantsiou, K.; Ortiz-Julien, A.; Bloem, A.; Dequin, S.; Camarasa, C. Specific phenotypic traits of Starmerella bacillaris related to nitrogen source consumption and central carbon metabolite production during wine fermentation. Appl. Environ. Microbiol. 2018, 84, 1–16. [Google Scholar] [CrossRef] [PubMed]
- Sadoudi, M.; Tourdot-Maréchal, R.; Rousseaux, S.; Steyer, D.; Gallardo-Chacón, J.J.; Ballester, J.; Vichi, S.; Guérin-Schneider, R.; Caixach, J.; Alexandre, H. Yeast-yeast interactions revealed by aromatic profile analysis of Sauvignon Blanc wine fermented by single or co-culture of non-Saccharomyces and Saccharomyces yeasts. Food Microbiol. 2012, 32, 243–253. [Google Scholar] [CrossRef] [PubMed]
- Jolly, N.P.; Varela, C.; Pretorius, I.S. Not your ordinary yeast: Non-Saccharomyces yeasts in wine production uncovered. FEMS Yeast Res. 2014, 14, 215–237. [Google Scholar] [CrossRef]
- Tofalo, R.; Patrignani, F.; Lanciotti, R.; Perpetuini, G.; Schirone, M.; Di Gianvito, P.; Pizzoni, D.; Arfelli, G.; Suzzi, G. Aroma profile of montepulciano d’abruzzo wine fermented by single and co-culture starters of autochthonous Saccharomyces and non-Saccharomyces yeasts. Front. Microbiol. 2016, 7, 1–12. [Google Scholar] [CrossRef]
- Medina, K.; Boido, E.; Fariña, L.; Gioia, O.; Gomez, M.E.; Barquet, M.; Gaggero, C.; Dellacassa, E.; Carrau, F. Increased flavour diversity of Chardonnay wines by spontaneous fermentation and co-fermentation with Hanseniaspora vineae. Food Chem. 2013, 141, 2513–2521. [Google Scholar] [CrossRef] [PubMed]
- Carrau, F.; Boido, E.; Ramey, D. Yeasts for Low Input Winemaking: Microbial Terroir and Flavor Differentiation, 1st ed.; Elsevier: Amsterdam, The Netherlands, 2020; Volume 111. [Google Scholar]
- Carrau, F.; Gaggero, C.; Aguilar, P.S. Yeast diversity and native vigor for flavor phenotypes. Trends Biotechnol. 2015, 33, 148–154. [Google Scholar] [CrossRef]
- Tempère, S.; Marchal, A.; Barbe, J.C.; Bely, M.; Masneuf-Pomarede, I.; Marullo, P.; Albertin, W. The complexity of wine: Clarifying the role of microorganisms. Appl. Microbiol. Biotechnol. 2018, 102, 3995–4007. [Google Scholar] [CrossRef]
- Albertin, W.; Zimmer, A.; Miot-Sertier, C.; Bernard, M.; Coulon, J.; Moine, V.; Colonna-Ceccaldi, B.; Bely, M.; Marullo, P.; Masneuf-Pomarede, I. Combined effect of the Saccharomyces cerevisiae lag phase and the non-Saccharomyces consortium to enhance wine fruitiness and complexity. Appl. Microbiol. Biotechnol. 2017, 101, 7603–7620. [Google Scholar] [CrossRef]
- Domizio, P.; Romani, C.; Lencioni, L.; Comitini, F.; Gobbi, M.; Mannazzu, I.; Ciani, M. Outlining a future for non-Saccharomyces yeasts: Selection of putative spoilage wine strains to be used in association with Saccharomyces cerevisiae for grape juice fermentation. Int. J. Food Microbiol. 2011, 147, 170–180. [Google Scholar] [CrossRef]
- Kim, D.H.; Lee, S.B.; Jeon, J.Y.; Park, H.D. Development of air-blast dried non-Saccharomyces yeast starter for improving quality of Korean persimmon wine and apple cider. Int. J. Food Microbiol. 2019, 290, 193–204. [Google Scholar] [CrossRef]
- Bagheri, B.; Zambelli, P.; Vigentini, I.; Bauer, F.F.; Setati, M.E. Investigating the effect of selected non-Saccharomyces species on wine ecosystem function and major volatiles. Front. Bioeng. Biotechnol. 2018, 6, 1–12. [Google Scholar] [CrossRef]
- De Filippis, F.; Aponte, M.; Piombino, P.; Lisanti, M.T.; Moio, L.; Ercolini, D.; Blaiotta, G. Influence of microbial communities on the chemical and sensory features of Falanghina sweet passito wines. Food Res. Int. 2019, 120, 740–747. [Google Scholar] [CrossRef]
- Englezos, V.; Cachón, D.C.; Rantsiou, K.; Blanco, P.; Petrozziello, M.; Pollon, M.; Giacosa, S.; Río Segade, S.; Rolle, L.; Cocolin, L. Effect of mixed species alcoholic fermentation on growth and malolactic activity of lactic acid bacteria. Appl. Microbiol. Biotechnol. 2019, 103, 7687–7702. [Google Scholar] [CrossRef]
- Horváth, B.O.; Sárdy, D.N.; Kellner, N.; Magyar, I. Effects of high sugar content on fermentation dynamics and some metabolites of wine-related yeast species Saccharomyces cerevisiae, S. uvarum and Starmerella bacillaris. Food Technol. Biotechnol. 2020, 58, 76–83. [Google Scholar] [CrossRef] [PubMed]
- Ferrando, N.; Araque, I.; Ortís, A.; Thornes, G.; Bautista-Gallego, J.; Bordons, A.; Reguant, C. Evaluating the effect of using non-Saccharomyces on Oenococcus oeni and wine malolactic fermentation. Food Res. Int. 2020, 138, 109779. [Google Scholar] [CrossRef]
- Englezos, V.; Rantsiou, K.; Giacosa, S.; Río Segade, S.; Rolle, L.; Cocolin, L. Cell-to-cell contact mechanism modulates Starmerella bacillaris death in mixed culture fermentations with Saccharomyces cerevisiae. Int. J. Food Microbiol. 2019, 289, 106–114. [Google Scholar] [CrossRef] [PubMed]
- Valera, M.J.; Morcillo-Parra, M.Á.; Zagórska, I.; Mas, A.; Beltran, G.; Torija, M.J. Effects of melatonin and tryptophol addition on fermentations carried out by Saccharomyces cerevisiae and non-Saccharomyces yeast species under different nitrogen conditions. Int. J. Food Microbiol. 2019, 289, 174–181. [Google Scholar] [CrossRef] [PubMed]
- Englezos, V.; Cravero, F.; Torchio, F.; Rantsiou, K.; Ortiz-Julien, A.; Lambri, M.; Gerbi, V.; Rolle, L.; Cocolin, L. Oxygen availability and strain combination modulate yeast growth dynamics in mixed culture fermentations of grape must with Starmerella bacillaris and Saccharomyces cerevisiae. Food Microbiol. 2018, 69, 179–188. [Google Scholar] [CrossRef]
- Caballero, A.; Segura, A. The quest for lower alcoholic wines. Microb. Biotechnol. 2017, 10, 238–241. [Google Scholar] [CrossRef]
- Andorrà, I.; Berradre, M.; Rozès, N.; Mas, A.; Guillamón, J.M.; Esteve-Zarzoso, B. Effect of pure and mixed cultures of the main wine yeast species on grape must fermentations. Eur. Food Res. Technol. 2010, 231, 215–224. [Google Scholar] [CrossRef]
- Englezos, V.; Rantsiou, K.; Cravero, F.; Torchio, F.; Pollon, M.; Fracassetti, D.; Ortiz-Julien, A.; Gerbi, V.; Rolle, L.; Cocolin, L. Volatile profile of white wines fermented with sequential inoculation of Starmerella bacillaris and Saccharomyces cerevisiae. Food Chem. 2018, 257, 350–360. [Google Scholar] [CrossRef] [PubMed]
- Russo, P.; Tufariello, M.; Renna, R.; Tristezza, M.; Taurino, M.; Palombi, L.; Capozzi, V.; Rizzello, C.G.; Grieco, F. New insights into the oenological significance of Candida zemplinina: Impact of selected autochthonous strains on the volatile profile of Apulian wines. Microorganisms 2020, 8, 628. [Google Scholar] [CrossRef]
- Pinto, L.; Malfeito-Ferreira, M.; Quintieri, L.; Silva, A.C.; Baruzzi, F. Growth and metabolite production of a grape sour rot yeast-bacterium consortium on different carbon sources. Int. J. Food Microbiol. 2019, 296, 65–74. [Google Scholar] [CrossRef]
- Prendes, L.P.; Merín, M.G.; Fontana, A.R.; Bottini, R.A.; Ramirez, M.L.; Morata de Ambrosini, V.I. Isolation, identification and selection of antagonistic yeast against Alternaria alternata infection and tenuazonic acid production in wine grapes from Argentina. Int. J. Food Microbiol. 2018, 266, 14–20. [Google Scholar] [CrossRef] [PubMed]
Publisher’s Note: MDPI stays neutral with regard to jurisdictional claims in published maps and institutional affiliations. |
© 2021 by the authors. Licensee MDPI, Basel, Switzerland. This article is an open access article distributed under the terms and conditions of the Creative Commons Attribution (CC BY) license (https://creativecommons.org/licenses/by/4.0/).